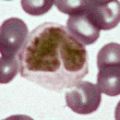
miniature

| <<< Août 2007 >>> | ||||||
| L | M | M | J | V | S | D |
| 1 | 2 | 3 | 4 | 5 | ||
| 6 | 7 | 8 | 9 | 10 | 11 | 12 |
| 13 | 14 | 15 | 16 | 17 | 18 | 19 |
| 20 | 21 | 22 | 23 | 24 | 25 | 26 |
| 27 | 28 | 29 | 30 | 31 | ||
| Sélectionner tout le mois | ||||||
Mars: le mystérieux trou noir est réellement un gouffre profond
Vendredi 31 Août 2007 à 00:00 | Spatial
Des cellules gliales capables de générer des neurones opérationnels
Vendredi 31 Août 2007 à 00:00 | Vie et Terre
Des fissures détectées sur des réservoirs des Navettes spatiales
Vendredi 31 Août 2007 à 00:00 | Spatial
Airbus livrera le premier A380 à Singapore Airlines le 15 octobre
Jeudi 30 Août 2007 à 00:54 | Aéronautique
Jupiter augmenterait le risque d'impacts de comètes sur Terre
Jeudi 30 Août 2007 à 00:00 | Astronomie
Filtrer les particules en suspension grâce aux mousses végétales
Mercredi 29 Août 2007 à 00:00 | Energie
Le télescope Spitzer fête ses 4 ans avec la nébuleuse de l'Hélix
Mardi 28 Août 2007 à 00:00 | Astronomie
Nissan: camera et renifleurs pour lutter contre l'alcool au volant
Lundi 27 Août 2007 à 00:12 | Transports
Fin de tempête sur Mars, Sprit et Opportunity retrouvent du tonus
Lundi 27 Août 2007 à 00:00 | Spatial
Des débits de 15 Gbit/s pour des réseaux sans fil personnels ?
Lundi 27 Août 2007 à 00:00 | Numérique
Navette spatiale: le matage des éléments de Discovery reporté
Vendredi 24 Août 2007 à 00:00 | Spatial
Photo: le reflex numérique classique le plus précis au monde
Jeudi 23 Août 2007 à 00:00 | Numérique
La stratégie du VIH pour se multiplier dans certains globules blancs
Jeudi 23 Août 2007 à 00:00 | Vie et Terre
Calvera: une étoile à neutrons "à proximité" de la Terre ?
Mercredi 22 Août 2007 à 00:00 | Astronomie
Des voitures de plus en plus attentives à leur environnement
Mardi 21 Août 2007 à 00:00 | Transports
Des particules qui changent de couleur sous champ magnétique
Dimanche 19 Août 2007 à 00:00 | Physique
Rétro 1937: La magie avait prévu ce que la science découvre...
Dimanche 19 Août 2007 à 00:00 | Archéologie
Un laboratoire sous marin de la NASA pour préparer les vols habités
Samedi 18 Août 2007 à 00:00 | Spatial
Déréglementation de l'UWB: des communications sans fil de 2 Gbps
Vendredi 17 Août 2007 à 00:08 | Numérique
La médaille Dirac 2007 pour les "inventeurs" du "quark charmé"
Lundi 13 Août 2007 à 00:00 | Physique
Des adhésifs chirurgicaux se substituant aux points de suture
Samedi 11 Août 2007 à 00:00 | Vie et Terre
Détection des plus lumineuses galaxies de l'univers lointain
Vendredi 10 Août 2007 à 00:00 | Astronomie
Condensateur monté à l'envers: la mission lunaire SELENE reportée
Jeudi 9 Août 2007 à 00:00 | Spatial
Un astronaute nommé au directoire de l'Agence spatiale allemande
Mercredi 8 Août 2007 à 00:00 | Spatial
Injection de nanoparticules dans une cellule à l'aide de nanotubes
Samedi 4 Août 2007 à 00:00 | Physique
Photovoltaïque: 360 millions d'euros pour booster la technologie
Vendredi 3 Août 2007 à 00:00 | Energie
La sonde européenne Mars Express surveillera l'américaine Phoenix
Jeudi 2 Août 2007 à 00:47 | Spatial
L'étoile supergéante crache des molécules indispensables à la vie
Mercredi 1er Août 2007 à 00:39 | Astronomie
La pertinence du modèle animal dans l'étude des maladies génétiques
Mercredi 1er Août 2007 à 00:00 | Vie et Terre
Tourisme spatial: dramatique accident chez Scaled Composites
Mercredi 1er Août 2007 à 00:00 | Spatial
Un revêtement anti-réfléchissant aux performances inégalées
Mercredi 1er Août 2007 à 00:00 | Physique
Aucun dossier répondant aux critères sélectionnés